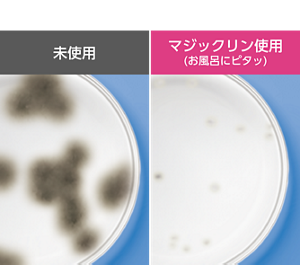
浴室内防カビ試験（培養プレート上）マジックリンお風呂にピタッ使用・未使用比較画像

カビ取り頑張っても…
繰り返すカビ・ピンクぬめり…

こうなる前に

*既にある汚れは除去してからお使いください。
*すべてのカビやピンクぬめりを抑制するわけではありません。

そもそもなぜ
お風呂のカビは繰り返すの?
お風呂のカビは繰り返すの?


カビの元となる胞子は
24時間どこからともなく入ってくる!


床や壁などで 胞子が根をはる。
成長した根が新たに 大量に胞子をばらまく


カビが黒く目立つように…。
そんな、カビの悩みに

お風呂にピタッの特長


※1 24時間換気、ドア閉の浴室での効果。
※2 すべてのカビやピンクぬめりを抑制するわけではありません。
※3 既にある汚れは除去してからお使いください。
実験結果に基づくイメージ。
すべてのカビに効果があるわけではありません。実験は、カビ胞子入り培地を、製品(低めの位置に配置)あり/なしの浴室(24時間換気、室温一定、ドア閉)に設置、一定期間培養し比較。
浴室全体に成分が広がる


*実際には、青色にはなりません。
82%がカビを生えにくくする効果が良かった!*
と回答しました!
と回答しました!

210人中173人がカビを生えにくくする効果が良かった*と回答しました
*商品のカビを生えにくくする効果はいかがでしたか?の質問に対して「よかった」「ややよかった」の合計
※2024年9月 花王調べ ご自身でお風呂そうじを週3回以上実施する20~60代女性210名が自宅の浴室で商品を6週間使用
だから
お風呂のキレイが約6週間続く!*
お風呂のキレイが約6週間続く!*
* 24時間換気、ドア閉めの浴室での効果。
すべてのカビやピンクぬめりを抑制するわけではありません。
既にある汚れは除去してからお使いください。
使い方は自由自在!
設置ラクラク


※4 タイルの壁など、磁石が貼れない壁もあります。


お子さんやペットが
届かない場所に貼れて便利!
交換もラクラク〜
使い方はこちら







丸い穴から液が見えなくなったら
交換の合図です!
塩素なし! 煙なし! 強い香りなし! の
ウォータベース処方
![]()
安心設計

※5使用開始直後は強く香ることがあります。
花粉や雨で外に干せない時
![]()
浴室干しの
生乾き臭対策にも

ラインナップ

本体
つけかえ用
Q&A

Q. 既に生えているカビを落とす効果もありますか?
回答を見る
A. 本製品はカビを生えにくくするもので、今あるカビを取り除くものではありません。既に発生しているカビなどの汚れは除去してからお使いください。カビ取りには強力カビハイターシリーズがおすすめです。
Q. 換気扇を使用しても、効果は持続しますか?
回答を見る
A. 24時間換気をしていた場合も、カビを生えにくくする効果は約6週間持続します。(使用状況により異なります。)ただし、換気扇の近くなど、浴室内に成分が広がりにくい場所への設置は、効果が得られにくい場合があるためおすすめしておりません。
Q. 窓を開けていても、効果は持続しますか?
回答を見る
A. 窓を開けていると、効果が得られにくい場合があるためおすすめしておりません。
Q. 設置している間、普段のお風呂そうじ(バスマジックリンやカビハイターなどを使用)をしても効果は持続しますか?
回答を見る
A. 約6週間効果は持続します。(使用状況により異なります。)
Q. カートリッジを交換するタイミングを忘れないためには、どうすればよいですか?
回答を見る
A. 商品に同梱されている「交換時期お知らせシール」に交換予定日を記載し、本体ケースやカレンダーに貼っていただくか、交換時期をスマホのカレンダーアプリに簡単に登録できる「マジックリン交換時期お知らせ機能」をご利用ください。詳しくはコチラから(https://www.kao.co.jp/magiclean/bath_boukabi/qr/)
Q. 製品の使用時に、浴室乾燥機を使っても大丈夫ですか?
回答を見る
A. 標準的な浴室乾燥機の使用時間(2~4時間程度)であれば問題なく、換気扇も通常通りにお使いいただけます。ただし浴室乾燥機を使い続ける、浴室乾燥機の温風が直接当たるなど、高温が続く場合は、製品や容器の品質に影響を及ぼす可能性があるため設置することができません。
Q. 製品の使用時に浴室で洗濯物を干した場合、衣類に香りは移りますか?
回答を見る
A. 洗濯物を干している状況によって異なりますが、微香性のため香りは移りにくい設計となっています。香り移りが気になる場合は、衣類を浴室から出してしばらく干しておくと、香りが気にならなくなります。
Q. 小さな子供やペットのいる家庭で使用しても大丈夫ですか?
回答を見る
A. 問題ありませんが、子供やペットが触れない場所に設置してください。磁石で壁に貼れるので高いところにも設置できて便利です。
Q. シャワーの水がかかっても大丈夫ですか?
回答を見る
A. 製品の品質や性能に影響する場合もあるため、なるべくシャワーの水などが直接かからない場所に設置してください。
Q. 浴室以外でも使えますか?
回答を見る
A. 用途外になりますので、浴室でご使用ください。
Q. 大浴場のような広い場所でも使えますか?
回答を見る
A. 一般家庭用の浴室でのみご使用ください。
Q. 浴室の広さによって使用個数は変わりますか?
回答を見る
A. 一般的な家庭の浴室(約1坪)であれば、1個で効果が発揮できるように設計しています。1つの浴室につき1個ご使用ください。










